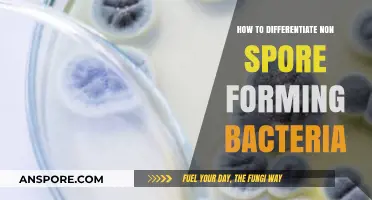
Identifying Non-Spore Forming Bacteria: Key Characteristics and Differentiation Techniques

In *Helldivers 2*, encountering the Spore Lung, a formidable enemy that releases deadly spores and poses a significant threat to your squad, requires a strategic and coordinated approach to neutralize effectively. Understanding its behavior, weaknesses, and the best tactics to exploit them is crucial for survival. This guide will delve into proven methods to destroy the Spore Lung, including weapon choices, team strategies, and environmental advantages, ensuring you and your fellow Helldivers emerge victorious against this hazardous foe.
| Characteristics | Values |
|---|---|
| Weakness | Fire Damage, Explosives |
| Resistance | Bullet Damage, Kinetic Damage |
| Effective Weapons | Flamethrowers, Incendiary Grenades, Orbital Strikes (Fire-based) |
| Tactics | Focus on setting the Spore Lung on fire, avoid close combat due to spore clouds, maintain distance |
| Spore Cloud Effect | Deals damage over time, reduces visibility |
| Size | Large |
| Mobility | Slow |
| Game | Helldivers 2 |
| Enemy Type | Automaton (Biomechanical) |
Explore related products
What You'll Learn
- Weak Points: Target spore lung's glowing sacs for massive damage and area denial
- Strategic Positioning: Stay mobile, avoid spore clouds, and flank for safer attacks
- Weapon Choice: Use fire or explosive weapons to destroy sacs efficiently
- Team Coordination: Focus fire on sacs simultaneously to prevent spore spread
- Environmental Leverage: Use terrain or explosives to collapse sacs from a distance

Weak Points: Target spore lung's glowing sacs for massive damage and area denial
The spore lung's glowing sacs are its Achilles' heel. These pulsating, bioluminescent orbs are not just a visual spectacle but a strategic target for Helldivers aiming to cripple this formidable enemy. Understanding their function is key: these sacs act as both a weapon and a life-support system for the spore lung, dispersing toxic spores and regenerating its health. By focusing your fire on these weak points, you can disrupt its offensive capabilities and significantly reduce its durability.
To effectively target the glowing sacs, prioritize precision over brute force. While heavy ordnance like orbital strikes or recoilless rifles can deal massive damage, they often result in collateral damage, including the destruction of the sacs themselves. Instead, opt for weapons that offer accuracy and controlled bursts, such as the stalwart laser cannon or the anti-materiel rifle. Aim for the sacs’ centers, as this area is less protected by the spore lung’s chitinous armor. A well-placed shot will not only rupture the sac but also trigger a chain reaction, causing the spore lung to expel its toxic payload prematurely, rendering it vulnerable.
Area denial is another critical benefit of targeting these sacs. When ruptured, the sacs release a cloud of spores that, while toxic to Helldivers, also disorient and slow the spore lung. This creates a temporary no-man’s-land around the creature, limiting its mobility and giving your squad a tactical advantage. To maximize this effect, coordinate with teammates to focus fire on multiple sacs simultaneously. This not only increases damage output but also expands the denial zone, effectively boxing the spore lung into a confined space where it can be neutralized with minimal risk.
However, caution is paramount. The spore lung will aggressively protect its sacs, often repositioning or summoning smaller spore carriers to distract attackers. Maintain a medium range to avoid its tendril attacks while staying within optimal firing distance. If the sacs are destroyed too quickly, the spore lung may enter a berserk state, increasing its attack speed and aggression. To counter this, stagger your attacks, leaving at least one sac intact until the creature is weakened. This ensures you retain control over the battlefield while gradually dismantling its defenses.
In summary, targeting the spore lung’s glowing sacs is a high-reward strategy that requires precision, coordination, and awareness. By exploiting these weak points, Helldivers can inflict massive damage, create strategic denial zones, and neutralize the threat with minimal casualties. Remember: accuracy trumps firepower, and timing is everything. Approach this tactic with discipline, and the spore lung will fall before your squad’s calculated assault.
Lycophyta Reproduction: Unveiling the Role of Spores in Their Life Cycle
You may want to see also

Strategic Positioning: Stay mobile, avoid spore clouds, and flank for safer attacks
In the chaotic battlefield of Helldivers 2, the Spore Lung presents a unique challenge, spewing toxic clouds that can quickly incapacitate your squad. Strategic positioning is your best defense and offense against this formidable enemy. Mobility is key—staying in one place makes you an easy target for its relentless spore attacks. Constant movement not only helps you avoid the toxic clouds but also disrupts the Spore Lung’s ability to focus its attacks on a single target. Think of it as a dance: you lead, it follows, and you exploit its momentary confusion to strike back.
Flanking is another critical tactic in this battle. The Spore Lung’s primary weapon is its spore cloud, which it projects in a forward arc. By attacking from the sides or rear, you minimize your exposure to this deadly ability. Coordinate with your team to create a pincer movement, drawing its attention in one direction while another diver moves in for a safer attack. For example, a Helldiver equipped with a flamethrower can engage the Spore Lung head-on, forcing it to focus on that threat, while a sniper flanks and targets its weak points. This division of roles maximizes damage while minimizing risk.
Avoiding spore clouds requires more than just running away—it demands spatial awareness and predictive movement. Watch the Spore Lung’s animation cues: its chest inflates before releasing a cloud, giving you a split second to dodge. Use cover strategically, but don’t rely on it for too long; the Spore Lung can reposition quickly, cutting off escape routes. If caught in a cloud, activate your booster immediately to minimize exposure. Pro tip: equip a respirator stratagem to reduce toxin damage, giving you a few extra seconds to escape or retaliate.
Finally, remember that strategic positioning isn’t just about survival—it’s about efficiency. Every second spent dodging spores is a second not spent dealing damage. By staying mobile, avoiding clouds, and flanking effectively, you turn the Spore Lung’s strengths into liabilities. Its size and slow turning radius become weaknesses when you exploit them with constant movement and coordinated attacks. This approach not only increases your chances of victory but also reduces the risk of friendly fire, a common pitfall in chaotic encounters. Master these tactics, and the Spore Lung will become just another obstacle on your mission to liberate the galaxy.
Can Raw Hamburger Produce Spores? Uncovering the Truth Behind Food Safety
You may want to see also

Weapon Choice: Use fire or explosive weapons to destroy sacs efficiently
Fire and explosive weapons are your best allies when facing the Spore Lung in *Helldivers 2*. The Spore Lung’s sacs are its weak point, and these weapons exploit their vulnerability to area damage and heat. Flamethrowers, for instance, deliver continuous fire damage, melting sacs with sustained exposure. A single well-aimed burst can ignite multiple sacs, especially when they cluster together. Explosive weapons like the Recoilless Rifle or Orbital Strike deal massive splash damage, ensuring even sacs out of direct line of sight are caught in the blast radius. Pairing these weapons with stratagems like the Napalm Strike amplifies their effectiveness, creating a fiery inferno that leaves no sac unscathed.
The choice between fire and explosives depends on the situation. Flamethrowers excel in close quarters, where sacs are densely packed and precision is less critical. Their area denial capability also prevents spores from spreading, giving your team breathing room. Explosives, however, shine in open environments or when sacs are scattered. A single grenade or rocket can clear a wide area, but timing and positioning are crucial to avoid wasting ammo. For maximum efficiency, combine both approaches: use explosives to thin out sacs from a distance, then move in with a flamethrower to mop up stragglers.
One practical tip is to prioritize sacs that are actively releasing spores, as these pose the most immediate threat. Look for the telltale green glow and target them first. If you’re using explosives, aim slightly above the sacs to ensure the blast wave hits them directly. For flamethrowers, maintain a steady stream of fire while circling the sacs to avoid taking damage from spores. Always keep an eye on your ammo count—flamethrowers consume fuel quickly, and explosives are limited in supply.
Caution is key when employing these weapons. Fire can spread to nearby terrain, potentially harming your team or triggering secondary hazards like fuel tanks. Explosives have a risk of friendly fire, especially in tight spaces. Communicate with your squad to coordinate attacks and avoid accidental damage. If you’re solo, use cover to your advantage and retreat if overwhelmed. Remember, the goal is to destroy sacs efficiently, not recklessly.
In conclusion, fire and explosive weapons are indispensable tools for dismantling the Spore Lung’s sacs. Their ability to deal area damage and exploit the sacs’ vulnerabilities makes them the most effective options. By understanding their strengths and limitations, you can tailor your approach to the battlefield and ensure a swift victory. Whether you’re scorching sacs with flames or obliterating them with explosions, these weapons will keep you one step ahead in the fight against the Spore Lung.
Exploring the Microscopic World: Can You Visualize a Spore's Image?
You may want to see also
Explore related products

Team Coordination: Focus fire on sacs simultaneously to prevent spore spread
In *Helldivers 2*, the Spore Lung's sacs are its most vulnerable and critical component. These sacs, when ruptured, release deadly spores that can quickly overwhelm your team. The key to neutralizing this threat lies in team coordination: focus fire on the sacs simultaneously to prevent spore spread. This strategy not only minimizes the risk of contamination but also ensures a swift and efficient takedown of the enemy.
Consider the mechanics of the Spore Lung: its sacs are its primary weapon, and destroying them disables its ability to disperse spores. When your team focuses fire on these sacs in unison, the concentrated damage overwhelms their structural integrity, causing them to burst before they can release their payload. This requires precise timing and communication. Assign roles beforehand—one player can call out the target sac, while others align their shots to hit it within a narrow time frame, ideally within 1-2 seconds of each other.
A practical example illustrates this approach: imagine a four-player squad facing a Spore Lung. Player 1, equipped with a high-damage railgun, takes the lead, firing at the largest sac. Players 2 and 3, using automatic rifles, follow immediately, ensuring their bullets land in quick succession. Player 4, armed with a grenade launcher, stands ready to detonate any sacs that survive the initial barrage. This coordinated effort ensures the sacs are destroyed before spores can spread, maintaining a clean battlefield.
However, caution is essential. Focus fire does not mean reckless firing. Stray shots can accidentally rupture sacs prematurely, releasing spores. Always aim for clean, precise hits, and avoid using area-of-effect weapons unless absolutely necessary. Additionally, maintain awareness of your surroundings—other enemies may exploit the chaos to flank your team. Positioning is critical; ensure your squad has clear lines of sight to the sacs while staying out of the Spore Lung’s melee range.
In conclusion, team coordination in focusing fire on the Spore Lung’s sacs is a game-changer. By synchronizing your attacks, you neutralize the spore threat efficiently, turning a potentially disastrous encounter into a manageable one. Practice this strategy, refine your timing, and communicate clearly to master this tactic. Remember, in *Helldivers 2*, unity is strength—and in this case, it’s the key to survival.
Activated Charcoal and Mold: Does It Attract or Repel Spores?
You may want to see also

Environmental Leverage: Use terrain or explosives to collapse sacs from a distance
In *Helldivers 2*, the Spore Lung's sacs are its Achilles' heel, but direct engagement often leads to hazardous spore clouds. Environmental leverage offers a safer, strategic alternative. By manipulating terrain or employing explosives, you can collapse these sacs from a distance, minimizing risk while maximizing efficiency. This approach requires keen observation and tactical planning, turning the battlefield itself into a weapon.
Steps to Execute Environmental Leverage:
- Identify Vulnerable Terrain: Look for elevated positions, weak structures, or areas where the sacs are precariously positioned. Cliffs, crumbling buildings, or unstable platforms are ideal.
- Position Explosives Strategically: Use grenades, orbital strikes, or other explosives to trigger a collapse. Aim for the base of the structure or directly beneath the sacs to ensure maximum impact.
- Time Your Attack: Coordinate with your team to distract enemies or clear the area before detonation. A well-timed strike prevents the Terminids from interfering with your plan.
Cautions to Consider:
Avoid placing yourself in the blast radius or beneath the sacs, as falling debris or collapsing structures can cause collateral damage. Additionally, be mindful of friendly fire if using orbital strikes or heavy explosives. Always assess the environment for unintended consequences, such as triggering nearby hazards or alerting enemy reinforcements.
Environmental leverage transforms the Spore Lung encounter from a direct confrontation into a puzzle of physics and positioning. By exploiting terrain weaknesses and using explosives judiciously, you can dismantle the sacs with minimal exposure to spores. This method not only preserves your team’s health but also showcases the game’s emphasis on creativity and adaptability in combat. Master this technique, and you’ll turn every battlefield into a tactical advantage.
Optimal Spores Count for Mastering Destiny 2's Leviathan Raid
You may want to see also
Frequently asked questions
The most effective stratagem is the Orbital Precision Strike, which deals massive damage in a concentrated area, making it ideal for destroying Spore Lungs quickly.
Yes, Spore Lungs can be destroyed with regular weapons, but it requires sustained firepower. Focus on the central core, as it is the weak point, and use high-damage weapons like the Recoilless Rifle or Railgun.
Destroy the Spore Lung quickly before it has a chance to release spores. If spores are already deployed, use Flamethrowers or Incendiary Mines to clear them out and prevent further spread.
Yes, the central core of the Spore Lung is its primary weakness. Focus all fire on this area to destroy it efficiently. Additionally, using Anti-Material Rifles or Orbital Strikes can exploit its vulnerability to high-impact damage.